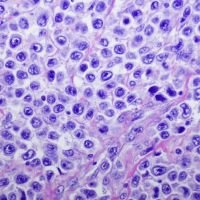
mantle cell lymphoma

Pirtobrutinib for relapsed or refractory mantle cell lymphoma (MCL) after at least two lines of systemic therapy, including a BTK inhibitor. Corresponding FDA Drug Update: Pirtobrutinib for relapsed or refractory mantle cell lymphoma (MCL)
What is the potential role for pirtobrutinib in the treatment of mantle cell lymphoma (MCL)?
Pirtobrtunib presents a third-line option for patients after receiving upfront induction therapy and second-line, irreversible (covalent) Bruton tyrosine kinase inhibitors (cBTKi).
- cBTKis currently include ibrutinib, acalabrutinib, or zanubrutinib.
Pirtobrutinib was approved based on the results of the BRUIN trial.1
- Phase 1/2 trial of pirtobrutinib in B-cell malignancies.
- 56 MCL patients included in efficacy analysis - objective response rate (ORR) in MCL was 52%.
- ORRs within patients with chronic lymphocytic leukemia (CLL) or small lymphocytic leukemia (SLL) were 63%.
- ORRs within patients with Waldenstrom macroglobulinemia (WM) were 68%.
- However, pirtobrutinib is only currently approved in MCL at this time.
Pirtobrutinib takes advantage of the mechanism of cBTKis but exists as a non-covalent, reversible BTKi, offering different pharmacodynamic properties that address cBTKi resistance in MCL.2
- cBTKi resistance in MCL most commonly occurs due to mutations in ATM, TP53, and N2D2, observed in up to 75% of patients who progress on ibrutinib.3,4
- Mutations in ATM, TP53, and N2D2 lead to alterations in the BTK 481 cysteine residue to which the cBTKis bind covalently causing resistance to cBTKi therapy.5
- Pirtobrutinib inhibits both wild-type and C481S mutant BTK.
- Mutations in ATM, TP53, and N2D2 lead to alterations in the BTK 481 cysteine residue to which the cBTKis bind covalently causing resistance to cBTKi therapy.5
- Outcomes after progression on BTKi are extremely poor, with a median overall survival of 6 to 10 months.6
- In the BRUIN trial, 93% of MCL patients had previously received a cBTKi and the ORR of MCL patients who received prior cBTKi therapy was found to be 52%.1
Currently, a phase III trial is underway for patients with relapsed/refractory mantle cell lymphoma that are BTKi naive.7
- Patients will be randomized to pirtobrutinib or investigator’s choice of cBTKi (ibrutinib, acalabrutinib, or zanubrutinib) following at least one line of systemic therapy for mantle cell lymphoma.
Pirtobrutinib is a category 2A recommended option for third line and subsequent therapy in the National Comprehensive Cancer Network (NCCN) guidelines for MCL.8 The other NCCN category 2A recommended treatment option in this space is brexucabtagene autoleucel.
What role can the pharmacist play in the management of patients on pirtobrutinib?
Pharmacists can play a critical role as part of monitoring to ensure patients on pirtobrutinib are receiving proper dosing, adequate supportive care for side effects, and regular intervals of lab monitoring.
- The recommended starting dose is 200 mg orally once daily.9
- Pirtobrutinib is renally cleared and thus requires renal dose adjustments.9
- eGFR <15-29 ml/min
- If taking 200 mg daily, reduce to 100 mg.
- If taking 100 mg daily, reduce to 50 mg.
- If taking 50 mg daily, discontinue.
- eGFR <15-29 ml/min
- Pirtobrutinib is renally cleared and thus requires renal dose adjustments.9
Cytopenias can occur which require management.9
- If any of the following occur while on 200 mg daily, interrupt therapy until recovery to grade 1 or baseline and then restart at original dosage.
- ANC < 1 - 0.5x109/L with fever and/or infection
- ANC < 0.5x109/L for 7 or more days
- Platelet count < 50 - 25x109/L with bleeding
- Platelet count < 25x109/L
- If any of the above occur for a second time while on 200 mg daily, interrupt therapy until recovery to grade 1 or baseline and then restart at 100 mg daily.
- If any of the above occur for a third time while on 100 mg daily, interrupt therapy until recovery to grade 1 or baseline and then restart at 50 mg daily.
- If any of the above occur for a fourth time, therapy should be discontinued.
Pirtobrutinib is a CYP3A4 substrate so it is recommended to avoid strong CYP3A4 inhibitors/inducers if possible while patients are on pirtobrutinib therapy.9
- CYP3A4 inhibitors
- If unavoidable, empirically dose reduce pirtobrutinib to 50 mg daily.
- If a patient is on 50 mg daily already, hold pirtobrutinib until the CYP3A4 inhibitor is stopped, wait for 5 CYP3A4 inhibitor elimination half-lives, then re-initiate pirtobrutinib.
- CYP3A4 inducers
- If unavoidable,
- For doses of 200 mg daily - increase to 300 mg daily.
- For doses of 50 mg or 100 mg daily - increase by 50 mg.
- If unavoidable,
Antibiotic, antiviral, and antifungal prophylaxis is recommended in patients at high risk for infection.9
- Grade 3 or higher infections occurred in 17% of 583 patients, most commonly pneumonia (9%), with fatal infections occurring in 4.1% of patients.
- The most common opportunistic infection was Pneumocystis jirovecii.
- Monitor blood counts routinely during treatment.
Secondary primary malignancies developed in 6% of 583 patients on pirtobrutinib, with the most common being non-melanoma skin cancer in 3.8% of 583 patients.9
- Advise patients to use sun protection.
The most common side effects with pirtobrutinib included neutropenia, upper respiratory tract infection, thrombocytopenia, anemia, hemorrhage, lymphopenia, rash, and myalgia
The most common grades 3 and 4 adverse events were neutropenia and anemia
Clinical Pearls
The original trial that led to pirtobrutinib approval, the BRUIN trial, was a phase I/II trial, not a phase III trial.1
Pirtobrutinib is efficacious for many patients who had received prior cBTKi; ORR was 62% for CLL/SLL patients, 52% for MCL patients, and 69% for WM patients.1
Atrial fibrillation/flutter is a rare but serious side effect noted in approval trials for ibrutinib, acalabrutinib, and zanubrutinib. While rates of atrial fibrillation/flutter were lower in the BRUIN trial for pirtobrutinib, this is a potential side effect that still requires adequate monitoring.1
A Jaypirca savings card can be obtained for copay assistance.10
References
1.Mato AR, Shah NN, Jurczak W, et al. Pirtobrutinib in relapsed or refractory B-cell malignancies (BRUIN): a phase 1/2 study. Lancet. 2021;397(10277):892-901. doi:10.1016/S0140-6736(21)00224-5.
2.Kumar A, Eyre TA, Lewis KL, Thompson MC, Cheah CY. New Directions for Mantle Cell Lymphoma in 2022. Am Soc Clin Oncol Educ Book. 2022;42:1-15. doi:10.1200/EDBK_349509.
3.Wang, L, Yang, P, Zhang, W, Wang, J. Clinical and Molecular Biology Analysis of Patients with Mantle Cell Lymphoma Resistant to BTK Inhibitor. Blood 2021; 138 (Supplement 1): 4527. doi: https://doi.org/10.1182/blood-2021-149114
4.Jain P, Kanagal-Shamanna R, Zhang S, et al. Long-term outcomes and mutation profiling of patients with mantle cell lymphoma (MCL) who discontinued ibrutinib. Br J Haematol. 2018;183(4):578-587. doi:10.1111/bjh.15567.
5.Naeem A, Utro F, Wang Q, et al. Pirtobrutinib targets BTK C481S in ibrutinib-resistant CLL but second-site BTK mutations lead to resistance. Blood Adv. 2023;7(9):1929-1943. doi:10.1182/bloodadvances.2022008447.
6.Burkart M, Karmali R. Relapsed/Refractory Mantle Cell Lymphoma: Beyond BTK Inhibitors. J Pers Med. 2022;12(3):376. Published 2022 Mar 1. doi:10.3390/jpm12030376.
7.Eyre TA, Shah NN, Dreyling M, et al. BRUIN MCL-321: phase III study of pirtobrutinib versus investigator choice of BTK inhibitor in BTK inhibitor naive mantle cell lymphoma. Future Oncol. 2022;18(36):3961-3969. doi:10.2217/fon-2022-0976.
8.National Comprehensive Cancer Network. B-Cell Lymphomas (Version 4.2023). https://www.nccn.org/professionals/physician_gls/pdf/b-cell.pdf. Accessed June 2, 2023.
9.Jaypirca (pirtobrutinib) [package insert]. Indianapolis, IN: Eli Lilly and Company; 2023.
10.Jaypirca Savings Card. https://www.jaypirca.com/savings-support. Accessed July 1, 2023.